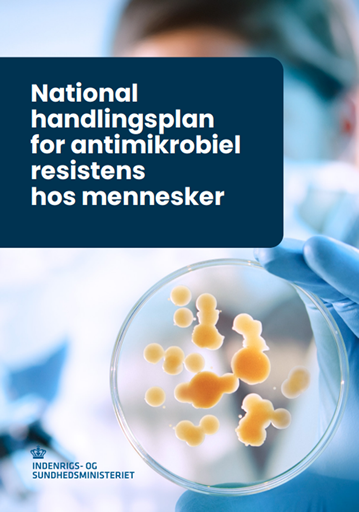
National handlingsplan for antimikrobiel resistens hos mennesker

Uge 46 - 2025
DANMAP 2024
DANMAP 2024
DANMAP-programmet overvåger antibiotikaforbrug og -resistens i bakterier fra mennesker, dyr og fødevarer i Danmark. DANMAP-samarbejdet har eksisteret siden 1995 og udgiver årligt nye rapporter, som beskriver de væsentligste fund vedrørende forbruget af antibiotika og forekomsten af antibiotikaresistens.
Nedenfor beskrives de vigtigste fund fra året 2024.
Antibiotika til mennesker
I 2024 var det samlede humane forbrug af antibiotika på 16,27 definerede døgndoser per 1.000 indbyggere per dag (DID), hvilket er sammenligneligt med forbruget i 2023 (16,47 DID), EPI-NYT 46/2024, men 7,3 % lavere end for 10 år siden (17,56 DID i 2015). Dette kan tyde på, at den observerede stigning i antibiotikaforbruget post-covid-19 er stoppet, figur 1.

Antibiotika i primærsektoren
I primærsektoren var forbruget af antibiotika 14,35 DID i 2024, hvoraf penicillinerne udgjorde 64 %. Forbruget af antibiotika til børn i primærsektoren steg markant fra 2021 til 2023, men i 2024 faldt forbruget igen betydeligt. Forbruget til de yngste børn mellem 0-4 år var 230 unikke personer, som har fået mindst én recept på antibiotika per 1.000 0-4-årige. Dette er 23 % lavere end i 2023 (298 patienter per 1.000 indbyggere). For de lidt ældre børn mellem 5-9 år er forbruget faldet med 13 % i samme periode fra 197 til 172 patienter per 1.000 indbyggere i hhv. 2023 og 2024, figur 2.

Figur 3 viser forbruget af antibiotika til behandling af luftvejsinfektioner, som faldt for første gang i 2024 (-7 % sammenlignet med 2023) efter et par år med et stigende forbrug post-covid-19. I vinteren 2022-2023 nåede den sædvanlige top i forbruget af antibiotika et højere niveau end observeret i 2018-2019. Dette skyldtes sandsynligvis en tidlig RSV-epidemi og influenzasæson samt et udbrud af gruppe A-streptokokinfektioner. De virale infektioner kan lede til sekundære bakterielle infektioner, som kræver behandling med antibiotika og kan dermed bidrage til det forhøjede forbrug af antibiotika.

Antibiotika til ældre patienter
Forbruget af antibiotika til ældre (≥ 65 år) på plejehjem var 93 % højere end forbruget til ældre i eget hjem i 2024, figur 4. Den største forskel ses i forbruget af antibiotika til behandling af urinvejsinfektioner. Forbruget til ældre har været faldende siden 2016, med et stejlere fald i forbruget til ældre på plejehjem. I 2024 var forbruget for første gang uændret sammenlignet med forbruget i det foregående år, 2023.

Antibiotika til hospitalspatienter
Tendensen i udviklingen af antibiotikaforbruget på hospitalerne afhænger af den anvendte måleenhed. I modsætning til primærsektoren er antibiotikaforbruget på hospitalerne det seneste årti steget fra 110,23 DDD/100 sengedage i 2015 til 146,17 i 2024 (+33 %) og fra 524,65 DDD/100 indlæggelser i 2015 til 593,31 i 2024 (+13 %). Målt i DDD/1.000 indbyggere/dag viste forbruget dog mindre markante ændringer i 2024 sammenlignet med for ti år siden.
Den observerede stigning målt i DDD/100 sengedage var drevet af et stigende forbrug af penicilliner kombineret med beta-laktamase-hæmmere (56 % stigning fra 2015 til 2024) og et stigende forbrug af beta-laktamase-resistente penicilliner (62 % stigning). I samme periode faldt forbruget af kritisk vigtige antibiotika (cephalosporiner, fluorquinoloner og carbapenemer) med 13 %, figur 5.
I 2024 var antibiotikaforbruget på hospitalerne for første gang i en lang årrække sammenligneligt med det foregående år. Mest i øjenfaldende er den knækkede kurve for forbruget af penicilliner kombineret med beta-laktamase-hæmmere, som faldt med 2 % fra 2023 til 2024, figur 5. Samtidig steg forbruget af beta-laktamase-sensitive penicilliner.

Antibiotika i restordre
Forsyningen med antibiotika er i stigende grad udfordret af leveringsvanskeligheder. I 2024 blev metronidazol ramt og var dermed utilgængeligt i en lang periode, hvilket man forsøgte at løse ved indkøb af ikke-registrerede præparater via udleveringstilladelse udstedt af Lægemiddelstyrelsen. Tidligere har penicillin/beta-laktamase-hæmmere og nitrofurantoin været ramt af leveringsvanskeligheder. Teamet bag DANMAP er engageret i en række nationale, nordiske og europæiske initiativer, som forsøger at løse problemerne med leveringsvanskeligheder for at bevare adgangen til antibiotika, især de ældre smalspektrede præparater.
Antibiotikaresistens i kliniske bakterier hos mennesker
Forekomsten af invasive bakterielle infektioner i Danmark var 12.214 tilfælde for de overvågede bakteriearter i 2024, figur 6. Forekomsten har været stigende i en lang årrække, men synes at være nået et stabilt niveau siden 2021. Sammenlignet med for 10 år siden er antallet af invasive bakterielle infektioner steget med 22 % (9.975 tilfælde i 2015). Escherichia coli var fortsat den mest hyppige årsag til invasive infektioner (50 % af alle tilfælde) i 2024, efterfulgt af Staphylococcus aureus og Klebsiella pneumoniae.
Vaccinationsindsatsen, både blandt børn og ældre/risikogrupper, har ført til en nedadgående forekomst af invasive infektioner med Streptococcus pneumoniae (747 tilfælde i 2015, 600 tilfælde i 2023), med markante fald i 2020 og 2021 (hhv. 363 og 333 samlede tilfælde) under covid-19-pandemien. Siden da er forekomsten steget igen.

Efter faldende resistensforekomster i en lang række overvågede bakteriearter under covid-19-pandemien, har resistensraterne siden 2022 været enten stabile eller stigende, men på et fortsat lavt niveau. Det er dog fortsat vigtigt at fokusere på at nedbringe antibiotikaforbruget, samt at behandle med så smalspektrede antibiotika som muligt.
Efter en betydelig nedgang i antal tilfælde af ESBL- og pAmpC-producerende E. coli i blodbanen fra 2020 til 2021 (hhv. 352 og 254 tilfælde), steg antallet til 336 i 2022 og 346 i 2023. Det er herefter faldet lidt til 316 tilfælde i 2024. CTX-M-15 forblev det hyppigste ESBL-enzym og var til stede i 40 % af tilfældene (57 % i 2023). Overvågning af disse E. coli er vigtig, idet ESBL- og/eller AmpC-positive bakterier er resistente over for de fleste betalaktam-antibiotika.
Det bør bemærkes, at resistensforekomsten mod piperacillin-tazobactam i K. pneumoniae er steget i de seneste 10 år og har overskredet 10 % både i invasive infektioner (5,9 % i 2015, 10,9 % i 2024) og urinvejsinfektioner (6,3 % i 2015 og 10,9 % i 2024) hos indlagte patienter.
Kombineret resistens over for 3. generations cefalosporiner, ciprofloxacin og gentamicin er fortsat sjælden for både E. coli og K. pneumoniae i invasive infektioner (hhv. 1,0 % og 1,4 % i 2024).
Antal carbapenemase producerende-organismer (CPO) steg med 15 % i 2024 (677 tilfælde) sammenlignet med 2023 (589 tilfælde). Den primære årsag til denne stigning er udbrud på danske hospitaler. Herudover bidrager intensiveret screening og modtagelse af ukrainske patienter også til stigningen. Der blev dog ikke indberettet rejseinformation for 27 % af patienterne, så tallene er behæftet med usikkerhed, figur 7.
Det er bekymrende, at der fortsat er høj smittespredning på hospitalerne. Det er derfor vigtigt fortsat at have fokus på de generelle og supplerende infektionshygiejniske forholdsregler i det daglige arbejde.

Mens der har været et fald i antallet af invasive infektioner med enterokokker siden 2022, er antallet af vancomycinresistente enterokokker (VRE) steget frem til 2022. I 2024 faldt forekomsten af VRE fra 722 isolater i 2023 til 613 isolater (15 % fald). Det fortsatte fald bør ikke føre til negligering af infektionsforebyggelse og -kontrol for at forebygge smitte og udbrud.
Efter en markant stigning i antallet af methicillinresistente S. aureus (MRSA)-tilfælde fra 2022 til 2023 (3.649 tilfælde), var der i 2024 et mindre fald til 3.372 tilfælde, EPI-NYT 43b/2025. MRSA-screening udgjorde 41 % af tilfældene, mens infektioner udgjorde 59 %. Der blev registreret 38 MRSA-udbrud på hospitaler, plejehjem og andre institutioner med i alt 191 tilfælde, hvoraf 86 var infektioner. Heraf udgjorde bakteriæmier 47 tilfælde, hvoraf 7 tilfælde var husdyrrelaterede.
Sammenhæng mellem antibiotikaforbrug og -resistens
I løbet af det seneste årti har mængden og sammensætningen af antibiotikaforbruget til mennesker ændret sig, efterfulgt af ændringer i resistensmønstre. Eksempelvis kan nævnes den stejle stigning i forbruget af penicilliner og beta-lactamasehæmmere på hospitaler og den samtidige stigning i resistens over for piperacillin-tazobactam i invasive Escherichia coli og Klebsiella pneumoniae, figur 8a. På den anden side har et faldende forbrug af fluoroquinoloner (ciprofloxacin) været efterfulgt af lavere resistens over for disse antibiotika i invasive Escherichia coli og Klebsiella pneumoniae, figur 8b.

Antibiotikaforbrug og -resistens i den veterinære sektor
På den veterinære side er der også sket interessante ændringer i forbruget af antibiotika og i resistensen i bakterier fra produktionsdyr og fødevarer. Eksempelvis kan nævnes, at i kølvandet på forbuddet mod zinkoxid i svineproduktionen, steg forbruget af antibiotika til smågrise i 2023. Denne stigning fortsatte ikke i 2024, hvor forbruget var sammenligneligt med 2023. Andelen af resistente E. coli udvundet fra grise fortsatte med at stige i 2024.
I kvæg steg antibiotikaforbruget med 4 % på trods af et fald i antallet af dyr. På den anden side udviste færre bakterier resistens over for de fleste testede antibiotika samtidig med, at andelen af multiresistente E. coli faldt med 10 procentpoint.
Læs meget mere om forbruget af antibiotika til dyr i DANMAP 2024 kapitel 4 og om resistens i bakterier fra produktionsdyr og fødevarer i kapitel 6, 7 og 9.
Ny national handlingsplan
Indenrigs- og Sundhedsministeriet udgav i juni 2025 National handlingsplan for antimikrobiel resistens hos mennesker. Den nye handlingsplan sætter rammen for en styrket og udvidet indsats mod antimikrobiel resistens. Handlingsplanen adresserer den humane sektor gennem 21 initiativer fordelt på følgende fire indsatsområder:
- Resistensbekæmpelse
- Forsyningssikkerhed
- Infektionsforebyggelse
- Internationalt engagement.
Læs mere om handlingsplanen: National handlingsplan for antimikrobiel resistens hos mennesker.
Vil du vide mere?
I anledning europæisk antibiotikadag og World Antimicrobial Awareness Week inviterer Statens Serum Institut og DTU Fødevareinstituttet til DANMAP-seminar den 18. november 2025, hvor der vil være fokus på væsentlige resultater fra DANMAP, nye handlingsplaner mod antibiotikaresistens og på hvordan man går fra handlingsplaner på papiret til handling i praksis.
Seminaret finder sted på Danmarks Tekniske Universitet og online fra kl. 10.30 til 14.30. Seminaret er relevant for alle fagpersoner, der enten udskriver antibiotika eller interesserer sig for antibiotikaforbrug og -resistens i Danmark. Tilmelding sker via dette link: www.danmap.org/da/seminars/seminar-2025.
Dele af DANMAP2024-rapporten kan allerede nu findes på www.danmap.org. Den fulde DANMAP2024 og Summary DANMAP2024 udgives den 18. november 2025.

(M. Attauabi, M. Lindegaard, U.W. Sönksen, Afdeling for Bakterier, Parasitter og Svampe)